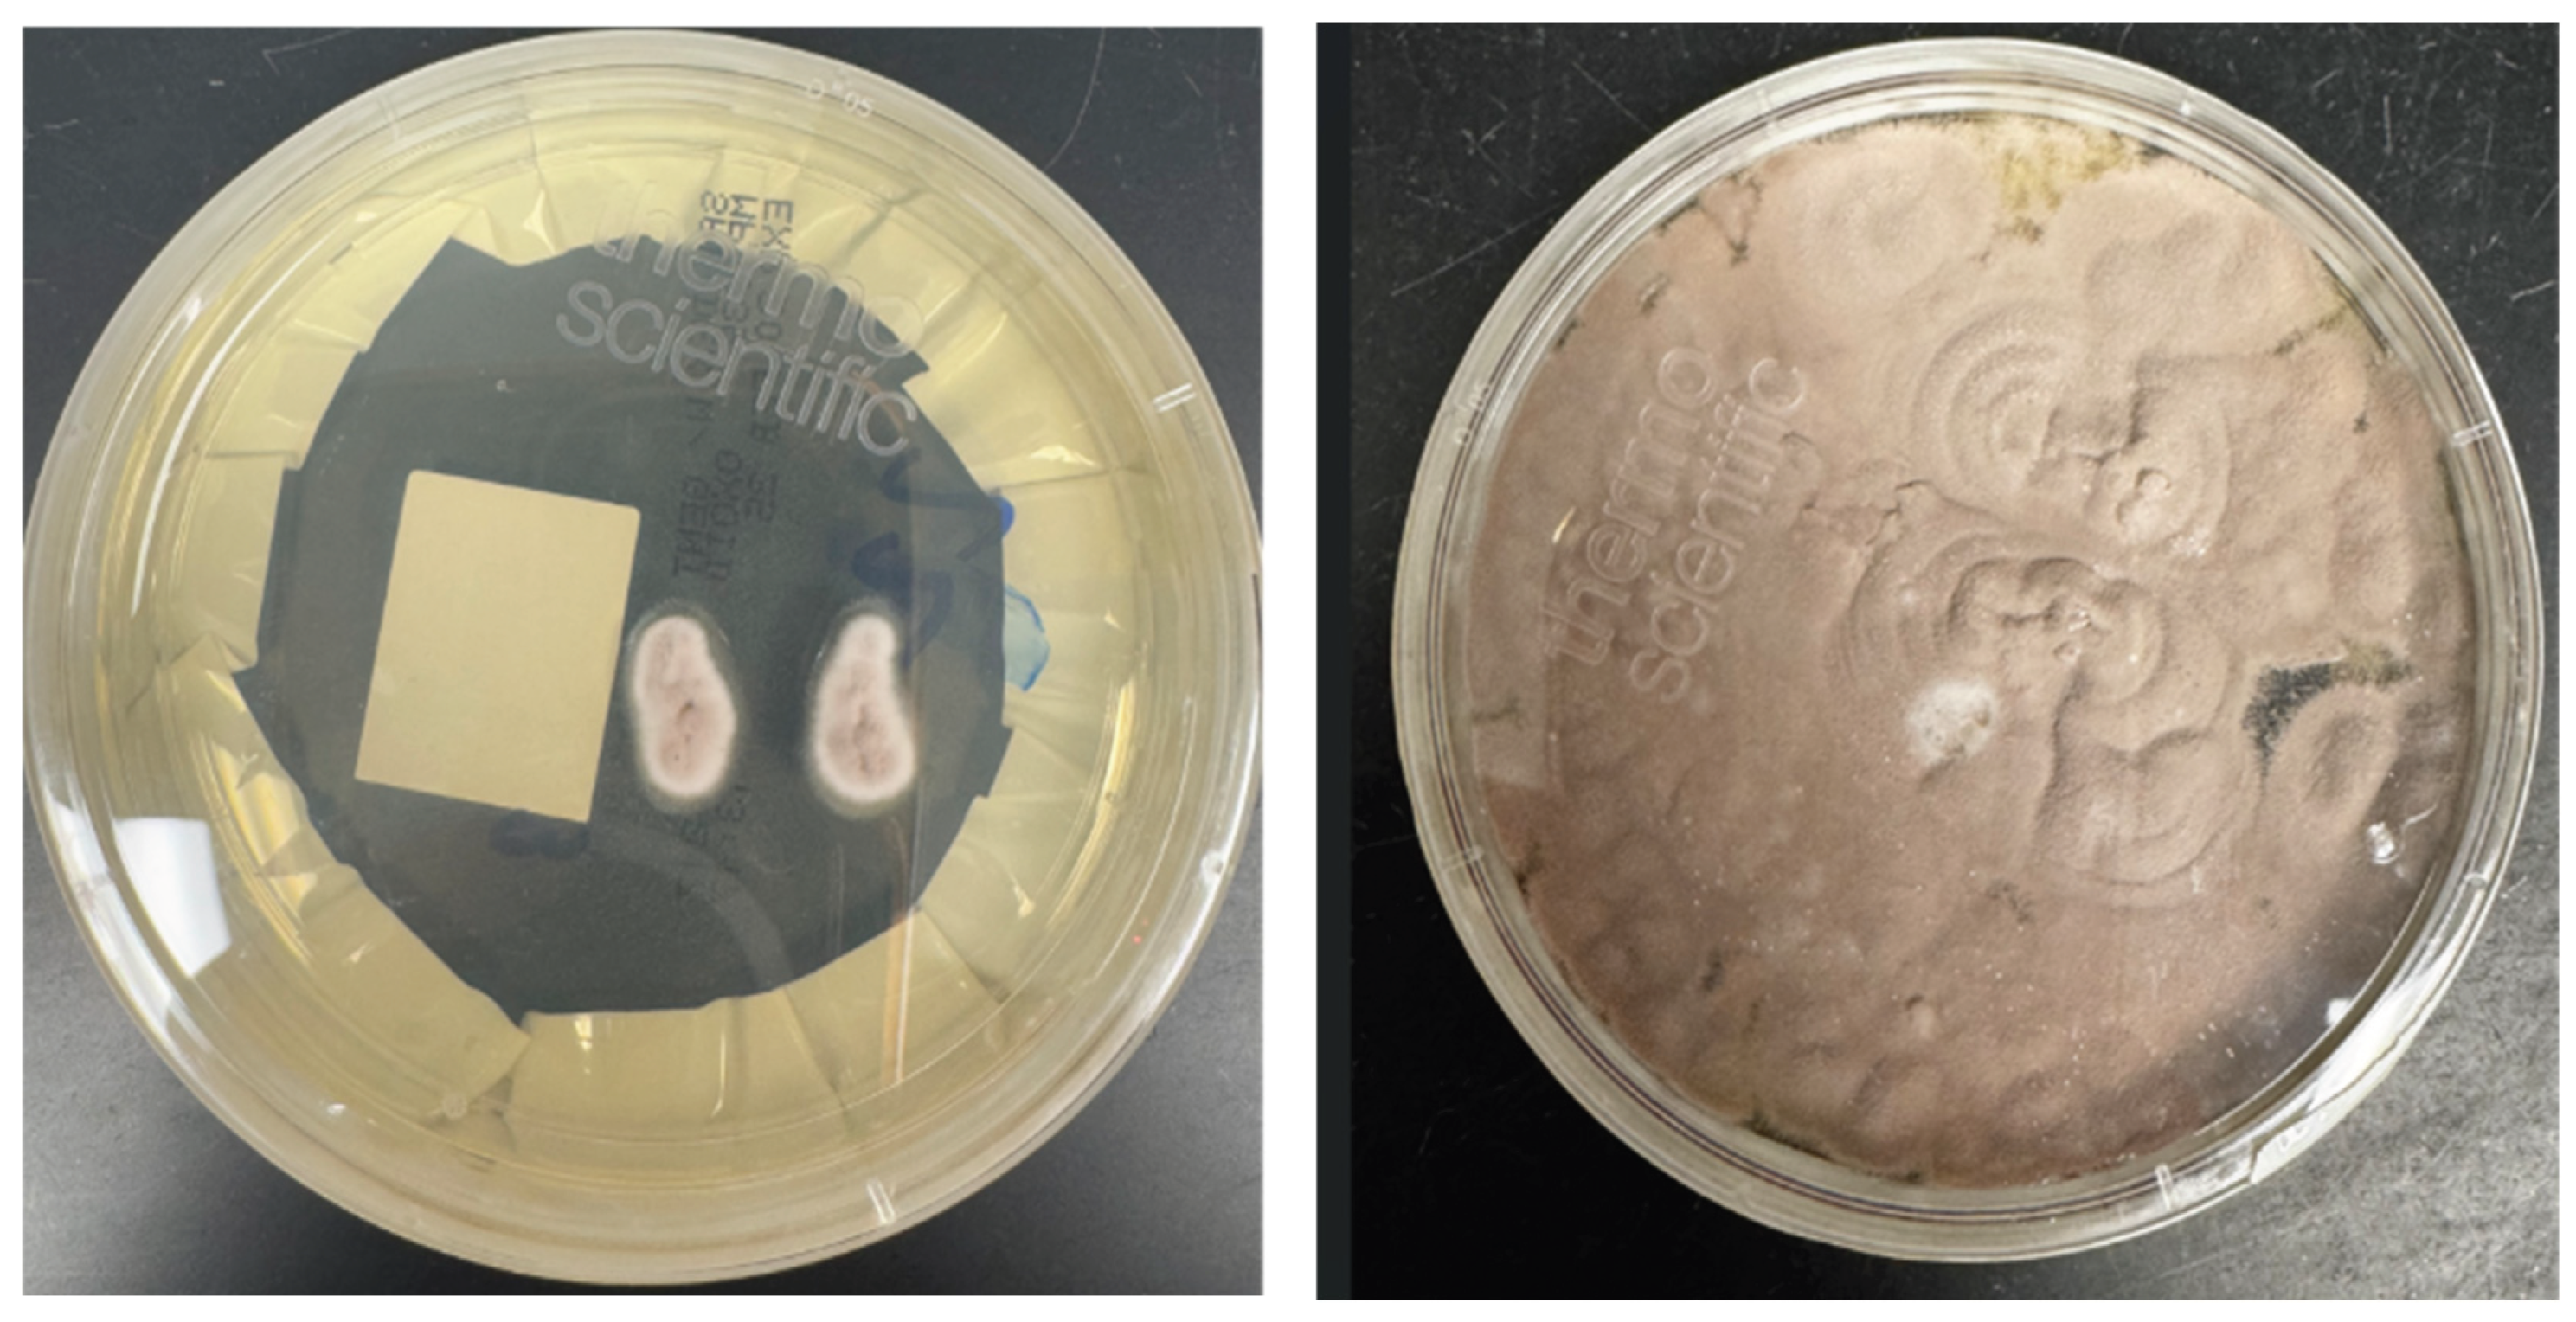
Preprints 179189 g003

1. Introduction
Purpureocillium lilacinum is a ubiquitous, hyaline hyphomycete found in soil and decaying organic matter. In recent years this species has been proven useful as a biocontrol agent against pests and for the promotion of plant growth[
1]. While once considered a rare contaminant, it is now recognized as an important opportunistic pathogen in humans [
1,
2,
3], particularly in the context of ocular infections [
3]. Ocular infection can manifest as keratitis [
3], scleritis [
6], or endophthalmitis [
5,
18] and is often associated with significant morbidity, including profound vision loss.
The primary risk factors for
P. lilacinum keratitis are ocular trauma [
5] and soft contact lens wear [
3,
4,
5]. Systemic conditions that impair immunity, such as diabetes mellitus and immunosuppression from underlying hematological malignancy, solid organ cancers, chemotherapy, and corticosteroid use further predispose individuals to severe and invasive disease [
7,
8].
P lilacinum has a predilection for ocular structures, thought to be due to a thermal tolerance of the fungus, with the optimum temperatures for growth and sporulation ranging from 20-25°C [
9]. A significant challenge in managing these infections is the organism’s intrinsic resistance to amphotericin B and echinocandins [
10,
11], leaving triazoles like voriconazole as the mainstay of therapy [
12,
13,
14]. However, treatment failures with voriconazole have been reported, linked to poor drug penetration or emerging resistance.
While cases of
P. lilacinum keratitis in diabetic or contact lens-wearing patients have been documented, reports detailing the progression to endophthalmitis requiring enucleation in a patient with this specific combination of risk factors are scarce in the literature [
15,
16,
17,
18]. We present a case report of a 70-year-old diabetic contact lens wearer who suffered this devastating outcome, with a focus on the microbiological diagnosis, therapeutic challenges, and public health context.
Case Presentation
A 70-year-old male with a 15-year history of sub-optimally controlled type 2 diabetes mellitus (most recent HbA1c 8.5%) and daily-wear soft contact lens user for over four decades presented to the ophthalmology clinic with a three-week history of escalating pain, photophobia, blurred vision and discharge from his right eye. He reported no recent trauma but admitted to occasional non-compliance with contact lens hygiene protocols.
On initial examination, there was notable right-sided conjunctival injection, without periorbital swelling or erythema. Visual acuity was 20/40 in the right eye. On fluorescein stain, a large ulcerated area with irregular edges at the 7 O’clock location of the central corneal area was noted. There was a crescent-shaped inferior nasal infiltrate with overlying epithelial defect measuring 5 mm x 2.9mm. The patient was otherwise systemically well and afebrile at the time.
Corneal scrapings were obtained from the base and edges of the ulcer for microbiological investigations including culture and sensitivity. The patient was given a contact lens holiday and administered topical vancomycin and tobramycin drops to the right eye on an hourly basis.
A corneal scraping was collected, with a portion smeared onto two glass slides for immediate microscopy, while the remainder was inoculated directly onto culture media. A 10% potassium hydroxide (KOH) with Fungi Fluor stain and Gram stain were prepared from the corneal scraping. Numerous septate, hyaline hyphal elements were visualized on direct Gram stain
Figure 1.
Direct microscopy of the corneal scrapings showing fungal elements.
Figure 1.
Direct microscopy of the corneal scrapings showing fungal elements.
Blood agar, Chocolate agar and Brain Heart infusion agar were inoculated with the corneal scrapings. Moderately fast fungal growth was observed on all the inoculated culture media, growing at both 30°C and 35°C. Growth was first observed at 48 hours, with colony maturation occurring in four to six days.
At 48 hours, rubbery raised greyish colonies were noticed on all the pre inoculated plates and these colonies were then subcultured onto a Sabouraud dextrose agar with gentamicin (SAB) using a sterile wooden needle, embedding the growing fungus slightly into the agar surface. Additionally, at that time a scotch tape mount was preformed, hyaline septate hyphae were observed.
After two days of incubation on SAB, the fungus was noted to be velvety and raised with a distinct lilac center and a white margin. A second tape mount was performed at the time and showed elongated thin phialides, with small oval conidia being released from the tip of the phialide in delicate chains. The elongated phialides were present both in small groups at the hyphal tip as well as along the edge of the hyphal surface. For rapid identification, an extract from the fungal colony was analyzed using Matrix-Assisted Laser Desorption/Ionization Time-of-Flight Mass Spectrometry (MALDI-TOF MS) with a Bruker Biotyper System and the Filamentous Fungi library (Billerica, Massachusetts, USA). The isolate was identified as P. lilacinum with a high-confidence score of 2.21.
Based on the distinctive lilac colony morphology, the presence of thin long phialides, and no reduction of growth at 35oC and MALDI-TOF, identification the fungus was reported as presumptive P. lilacinum. To provide definitive confirmation and for epidemiological purposes, the isolate was sent to a public health reference laboratory. The patient had a temporary tarsorrhaphy of the right eye two weeks later for relief. The patient tolerated the procedure well.
Figure 2.
Illustrative Microscopic Morphology of Purpureocillium lilacinum (A) Lactophenol stain of a tape mount from culture, demonstrating characteristic phialides with swollen bases and long, tapering necks. (B) Chains of oval conidia produced from the phialides.
Figure 2.
Illustrative Microscopic Morphology of Purpureocillium lilacinum (A) Lactophenol stain of a tape mount from culture, demonstrating characteristic phialides with swollen bases and long, tapering necks. (B) Chains of oval conidia produced from the phialides.
Figure 3.
a and b Colony morphology on SAB at 48 hours and 120 hours respectively, velvety and raised colony with a distinct lilac center and a white margin.
Figure 3.
a and b Colony morphology on SAB at 48 hours and 120 hours respectively, velvety and raised colony with a distinct lilac center and a white margin.
After microbiological identification of P. lilacinum, topical tobramycin was discontinued while topical voriconazole was initiated. Over the subsequent two months, the patient’s clinical course was marked by relentless progression. The stromal infiltrate opacified the entire cornea, and signs of scleral and intraocular extension became evident, with the development of vitreous opacities and retinal elevation leading to the possibility of endophthalmitis on B-scan ultrasonography. Oral voriconazole (200 mg twice daily) was added to the topical regimen.
A vitreous tap was done at this time and intravitreal voriconazole, amphotericin B, ceftazidime and vancomycin was given. The intravitreal tap sample also grew P. lilacinum. The diagnosis was again based on the combination of microscopic observations, culture findings, and MALDI-TOF. Culture growth was sent to Public Health Ontario Laboratory for posaconazole and voriconazole susceptibility testing using the Clinical and Laboratory Standards Institute (CLSI) M38-A3 broth microdilution method. Both voriconazole and posaconazole had a minimum inhibitory concentration of 0.5 μg/ml.
The patient was therefore continued on both oral and topical voriconazole. Despite this dual therapy, the infection evolved into panophthalmitis, characterized by intractable pain, proptosis, and complete loss of light perception. Given the uncontrolled infection, severe pain, and lack of visual potential, the decision was made to proceed with enucleation of the right eye.
Discussion
Purpureocillium lilacinum is an emerging ocular mold that, although infrequently isolated [
10], may carry a disproportionate risk of catastrophic visual loss [
15,
20,
22]. Contemporary series estimate its incidence at 1–4% of culture-positive fungal keratitis, yet it accounts for up to 15% of filamentous fungal keratitis cases ultimately requiring evisceration or enucleation [
10,
18], highlighting its aggressive pathogenic potential. In the present case, the convergence of advanced age, poorly controlled diabetes mellitus, and soft contact lens wear culminated in globe sacrifice despite prompt laboratory confirmation and guideline-based antifungal therapy. Diabetes mellitus compromises neutrophil function, disrupts corneal epithelial integrity, and creates a hyperglycaemic periocular microenvironment, while contact lenses provide an abiotic surface conducive to biofilm formation and a direct route for fungal inoculation [
6,
12]. The interplay of these factors likely accelerated corneal invasion and posterior extension in our patient.
Expedited species-level identification is particularly critical in the
Purpureocillium genus, as pathogenic potential and antifungal susceptibility vary markedly among species [
10,
19,
23,
24]. Amphotericin B is least active against
P. lilacinum isolates and higher mortality has been noted in patients treated with Amphotericin B [
10] distinguishing it from
P. variotii, which generally retains broader antifungal susceptibility and is associated with less severe ocular disease. In this case, MALDI-TOF mass spectrometry [
19,
24] performed within 24 hours of colony growth allowed rapid species-level confirmation and timely initiation of high-dose voriconazole [
24]. Notwithstanding the isolate’s minimum inhibitory concentration of 0.5 µg/mL, the infection progressed to endophthalmitis despite aggressive dosing, highlighting that even isolates with in vitro susceptibility profiles deemed to be favourable as per prior studies [
10] may fail clinically when posterior extension occurs. A critical corollary is that when disease progression is evident, clinicians should maintain a low threshold for early surgical intervention [
28], such as therapeutic penetrating keratoplasty (TPK), as medical salvage rates decline sharply once the posterior segment is seeded.
Table 1.
Comparative features of Purpureocillium lilacinum and Purpureocillium variotii.
Table 1.
Comparative features of Purpureocillium lilacinum and Purpureocillium variotii.
| Feature |
P. lilacinum |
P. variotii |
| Epidemiology |
Rare cause of human infection; disproportionately represented among severe filamentous keratitis and post-surgical ocular mold infections; increasingly reported in contact lens–associated keratitis [15]. |
Less frequently associated with ocular disease; more common in onychomycosis, cutaneous infections, and respiratory colonization; ocular involvement is rare [24]. |
| Morphology (Culture) |
Colonies typically fast-growing (2-3 days), lilac to violet with a velvety texture; conidiophores slender and branched, with chains of elliptical conidia [21]. |
Colonies pale to tan or yellow-brown in 2-3 days; conidiophores thicker, producing ellipsoidal to oblong conidia; morphology less distinctive in early growth [21]. |
| Molecular Identification |
ITS sequencing and MALDI-TOF MS can reliably distinguish from P. variotii; closely related to other Purpureocillium spp. [19,25]. |
Similarly identifiable via ITS sequencing and MALDI-TOF MS; often misidentified morphologically without molecular tools [19,25]. |
| Antifungal Susceptibility |
High MICs noted for amphotericin B, fluconazole, itraconazole and flucytosine. Echinocandins show poor or variable activity. Voriconazole and posaconazole display the most reliable in vitro efficacy, with posaconazole typically yielding the lowest MICs. However, in vitro susceptibility does not always correlate with clinical outcome, particularly in deep-seated ocular infections [12,15,19,27,29]. |
Typically broader susceptibility than P. lilacinum; generally responsive to amphotericin B, echinocandins, and triazoles (voriconazole, posaconazole, isavuconazole). Clinical outcomes more favorable with standard antifungal therapy [19,24]. |
| Therapeutic Implications |
Requires early species-level identification to guide therapy; triazoles are first-line, but treatment failure may occur even with deemed susceptible-range MICs [28]. |
Broader therapeutic options available; standard antifungal classes (including amphotericin B) may be effective |
| Clinical Course in Ocular Disease |
Often aggressive with rapid corneal invasion and potential posterior extension; higher likelihood of requiring surgical intervention (TPK, enucleation) [28] |
Slower progression; less frequently associated with globe-sacrificing outcomes; better prognosis with early antifungal therapy [24] |
Distinguishing
P. lilacinum from other
Purpureocillium species early in the diagnostic workflow is critical for guiding therapy, anticipating potential treatment failure, and determining the optimal timing for surgical intervention [
28]. In vitro MIC data alone may not predict clinical outcomes, particularly in high-risk patients or when posterior extension is imminent. The lack of established clinical breakpoints for
P. lilacinum complicates interpretation of MIC data interpretation, knowledge of clinical context, site of infection, PK/PD of antifungal drugs and patients immune status are therefore critical for therapeutic decision making. [
10,
24]
Epidemiologic observations further emphasize the need for vigilance. A 2024 outbreak in a New York City ophthalmology clinic, involving 23 cases of keratitis linked to contaminated instrumentation, demonstrates both the outbreak potential of this mold and the importance of immediate public health notification upon isolation [
26]. In this cluster, as in the present case, soft contact lens wear and antecedent topical corticosteroid use were the most common predisposing factors. These findings highlight the necessity of rigorous patient education regarding contact lens hygiene and the routine referral of rare ocular mold isolates to reference laboratories, both for definitive species identification and contribution to regional surveillance networks capable of detecting clonal spread [
26].
Finally, the case underscores the importance of a multidisciplinary approach [
29]. Infectious diseases consultation facilitated dose optimization and drug-level monitoring, while corneal and vitreoretinal surgeons provided real-time assessment of surgical thresholds [
29]. Such coordinated care should be regarded as the standard for
P. lilacinum ocular infection, given the narrow therapeutic window before irreversible structural and functional damage occurs.
This report reinforces P. lilacinum as a low-incidence yet high-consequence ocular pathogen. The severe clinical course observed in a diabetic contact lens wearer, culminating in enucleation despite rapid diagnosis and guideline-concordant therapy, highlights three actionable imperatives: maintain a high index of suspicion when risk factors converge, expedite species-level identification to guide triazole therapy, and adopt an early, assertive surgical strategy when MICs are elevated, or posterior extension is imminent. In fungal keratitis, time is vision and with P. lilacinum, delay may cost the eye itself.
Author Contributions
Conceptualization, Sara Calendino, Jennifer Kenna, Hetal Patel, Jenny Vereecken and Ruchika Bagga; Methodology, Jennifer Kenna and Ruchika Bagga; Investigation, Ruchika Bagga; Resources, Sara Calendino, Jenny Vereecken and Ruchika Bagga; Data curation, Sara Calendino, Jennifer Kenna, Hetal Patel, Jenny Vereecken, Fatimah Almutawa, Jeff Fuller, Johan Delport, Sameer Elsayed and Ruchika Bagga; Writing—original draft, Sara Calendino, Jennifer Kenna, Hetal Patel, Jenny Vereecken and Ruchika Bagga; Writing—review & editing, Sara Calendino, Jennifer Kenna, Hetal Patel, Jenny Vereecken, Fatimah Almutawa, Jeff Fuller, Johan Delport, Sameer Elsayed and Ruchika Bagga; Supervision, Jenny Vereecken and Ruchika Bagga; Project administration, Ruchika Bagga.
Funding
Please add: This research received no external funding.
Data Availability Statement
The original contributions presented in this study are included in the article. Further inquiries can be directed to the corresponding author.
Acknowledgments
Not applicable
Conflicts of Interest
The authors declare no conflict of interest.
References
- Khan M, Tanaka K. Purpureocillium lilacinum for plant growth promotion and biocontrol against root-knot nematodes infecting eggplant. PLoS One. 2023;18(3):e024. [CrossRef]
- Luangsa-Ard J, Houbraken J, van Doorn T, et al. Purpureocillium, a new genus for the medically important Paecilomyces lilacinus. FEMS Microbiol Lett. 2011;321:141–9. [CrossRef]
- Maharana PK, Sharma N, Nagpal R, et al. Recent advances in diagnosis and management of Mycotic Keratitis. Indian J Ophthalmol. 2016;64:346–57. [CrossRef]
- Stapleton F, Naduvilath T, Keay L, et al. Risk factors and causative organisms in microbial keratitis in daily disposable contact lens wear. PLoS One. 2017;12:e0174762. [CrossRef]
- Petit TH, Olson RJ, Food RY, et al. Fungal endophthalmitis following intraocular lens implantation. Arch Ophthalmol. 1980;98:1025–39.
- Chung PC, Lin HC, Hwang YS, Tsai YJ, Ngan KW, Huang SC, Hsiao CH. Paecilomyces lilacinus scleritis with secondary keratitis. Cornea. 2007 Feb;26(2):232-4. PMID: 17251822. [CrossRef]
- Itin PH, Frei R, Lautenschlager S, et al. Cutaneous manifestations of Paecilomyces lilacinus infection induced by a contaminated skin lotion in patients who are severely immunosuppressed. J Am Acad Dermatol. 1998;39:401–9. [CrossRef]
- Orth B, Frei R, Itin PH, et al. Outbreak of invasive mycoses caused by Paecilomyces lilacinus from a contaminated skin lotion. Ann Intern Med. 1996;125:799–806. [CrossRef]
- Stephan Z, Al-Din SS. Influence of temperature and culture media on the growth of the fungus Paecilomyces lilacinus. Revue de Nematol. 1987;10:494.
- Sprute R, Salmanton-García J, Sal E, Malaj X, Ráčil Z, Ruiz de Alegría Puig C, Falces-Romero I, Barać A, Desoubeaux G, Kindo AJ, Morris AJ, Pelletier R, Steinmann J, Thompson GR, Cornely OA, Seidel D, Stemler J; FungiScope® ECMM/ISHAM Working Group. Invasive infections with Purpureocillium lilacinum: clinical characteristics and outcome of 101 cases from FungiScope® and the literature. J Antimicrob Chemother. 2021 May 12;76(6):1593-1603. PMID: 33599275; PMCID: PMC8120338. [CrossRef]
- Castro LG, Salebian A, Sotto MN. Hyalohyphomycosis by Paecilomyces lilacinus in a renal transplant patient and a review of human Paecilomyces species infections. J Med Vet Mycol. 1990;28(1):15–26. [CrossRef]
- Thiel MA, Zinkernagel AS, Burhenne J, et al. Voriconazole concentration in human aqueous humor and plasma during topical or combined topical and systemic administration for fungal keratitis. Antimicrob Agents Chemother. 2007;51:239–44. [CrossRef]
- Corrêa-Moreira D, de Lima Neto RG, da Costa GL, et al. Purpureocillium lilacinum, an emergent pathogen: antifungal susceptibility of environmental and clinical strains. Lett Appl Microbiol. 2022;75:45–50. [CrossRef]
- Almeida Oliveira M, Carmo A, Rosa A, Murta J. Posaconazole in the treatment of refractory Purpureocillium lilacinum (former Paecilomyces lilacinus) keratitis: the salvation when nothing works. BMJ Case Rep. 2019 Apr 11;12(4):e228645. PMID: 30975779; PMCID: PMC6505977. [CrossRef]
- Chew R, Dorman A, Woods ML. Purpureocillium lilacinum keratitis: a case series and review of the literature. Can J Ophthalmol. 2016 Oct;51(5):382-385. Epub 2016 Sep 3. PMID: 27769331. [CrossRef]
- Lee GA, Whitehead K, McDougall R. Management of Paecilomyces keratitis. Eye (Lond). 2007;21:262–4. [CrossRef]
- Maier P, Betancor PK, Reinhard T. Contact Lens–Associated Keratitis—an Often Underestimated Risk. Dtsch Arztebl Int. 2022;119:669–74.
- Lu X, Ng DS, Zheng K, Peng K, Jin C, Xia H, Chen W, Chen H. Risk factors for endophthalmitis requiring evisceration or enucleation. Sci Rep. 2016 Jun 15;6:28100. PMID: 27302573; PMCID: PMC4908388. [CrossRef]
- Monpierre, L.; Aït-Ammar, N.; Valsecchi, I.; Normand, A.-C.; Guitard, J.; Riat, A.; Huguenin, A.; Bonnal, C.; Sendid, B.; Hasseine, L.; et al. Species Identification and In Vitro Antifungal Susceptibility of Paecilomyces/Purpureocillium Species Isolated from Clinical Respiratory Samples: A Multicenter Study. J. Fungi 2022, 8, 684. [CrossRef]
- Bennett HY, Shah SP. A case of non-traumatic Purpureocillium lilacinum endophthalmitis in a child. Am J Ophthalmol Case Rep. 2022;26:101375.
- De Hoog GS, Guarro J, Gene J, Figueras MJ. Atlas of clinical fungi, 2nd ed. Centraal bureau Voor Schimmelcultures. 2000;794–809.
- Turner LD, Conrad D. Retrospective case-series of Paecilomyces lilacinus ocular mycoses in Queensland, Australia. BMC Res Notes. 2015;8:627. [CrossRef]
- Aguilar C, Pujol I, Sala J, Guarro J. Antifungal susceptibilities of Paecilomyces species. Antimicrob Agents Chemother. 1998 Jul;42(7):1601-4. PMID: 9660991; PMCID: PMC105653. [CrossRef]
- Sprute R, Salmanton-García J, Sal E, Malaj X, Falces-Romero I, Hatvani L, Heinemann M, Klimko N, López-Soria L, Meletiadis J, Shruti M, Steinmann J, Seidel D, Cornely OA, Stemler J. Characterization and outcome of invasive infections due to Paecilomyces variotii: analysis of patients from the FungiScope® registry and literature reports. J Antimicrob Chemother. 2021 Feb 11;76(3):765-774. PMID: 33254240; PMCID: PMC7879145. [CrossRef]
- Barker, A. P., Horan, J. L., Slechta, E. S., Alexander, B. D., & Hanson, K. E. (2014). Complexities associated with the molecular and proteomic identification of Paecilomyces species in the clinical mycology laboratory. Med Mycol, 52(5), 537–545. [CrossRef]
- 2024; 26. Purpureocillium lilacinum Keratitis Cases Associated with an Ophthalmology Clinic — New York City, 2024 | EIS Conference | CDC.
- D. Corrêa-Moreira, R.G. de Lima Neto, G.L. da Costa, C. de Moraes Borba, M.M.E. Oliveira, Purpureocillium lilacinum an emergent pathogen: antifungal susceptibility of environmental and clinical strains, Letters in Applied Microbiology, Volume 75, Issue 1, 1 July 2022, Pages 45–50. [CrossRef]
- Pastor FJ, Guarro J. Clinical manifestations, treatment and outcome of Paecilomyces lilacinus infections. Clin Microbiol Infect. 2006 Oct;12(10):948-60. PMID: 16961630. [CrossRef]
- Garbino, J., Ondrusova, A., Baligvo, E., Lew, D., Bouchuiguir-Wafa, K., & Rohner, P. (2002). Successful Treatment of Paecilomyces lilacinus Endophthalmitis with Voriconazole. Scandinavian Journal of Infectious Diseases, 34(9), 701–703. [CrossRef]
|
Disclaimer/Publisher’s Note: The statements, opinions and data contained in all publications are solely those of the individual author(s) and contributor(s) and not of MDPI and/or the editor(s). MDPI and/or the editor(s) disclaim responsibility for any injury to people or property resulting from any ideas, methods, instructions or products referred to in the content. |
© 2025 by the authors. Licensee MDPI, Basel, Switzerland. This article is an open access article distributed under the terms and conditions of the Creative Commons Attribution (CC BY) license (http://creativecommons.org/licenses/by/4.0/).